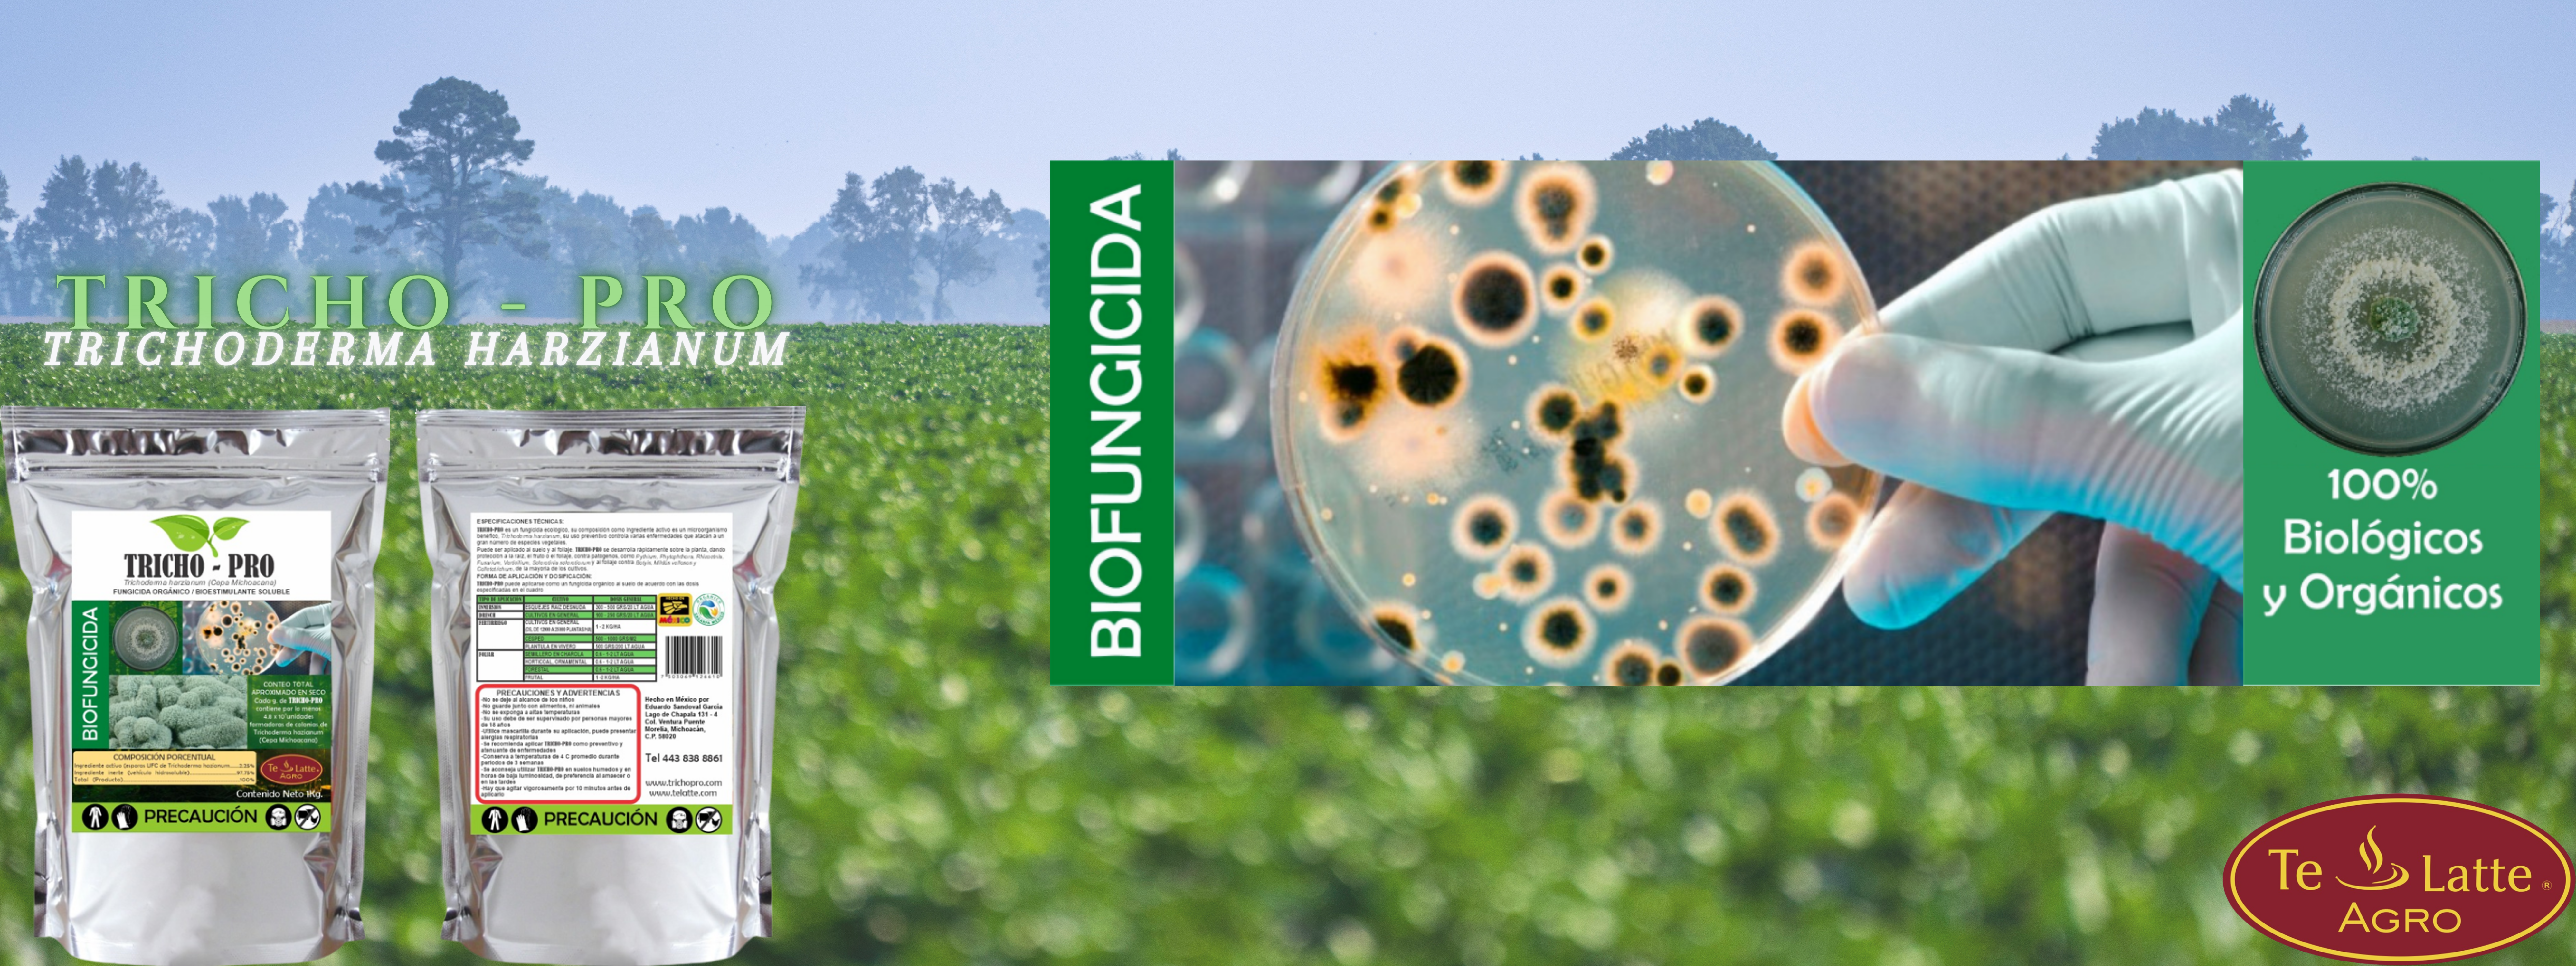

BIO FUNGICIDA ORGANICO - TRICHO PRO
 TRICHO-PRO es un fungicida ecológico, su composición
como ingrediente activo es un microorganismo benéfico,
Trichoderma harzianum, su uso preventivo controla varias
enfermedades que atacan a un gran número de especies
vegetales.
TRICHO-PRO es un fungicida ecológico, su composición
como ingrediente activo es un microorganismo benéfico,
Trichoderma harzianum, su uso preventivo controla varias
enfermedades que atacan a un gran número de especies
vegetales.
 Puede ser aplicado al suelo y al Follaje, TRICHO-PRO
se desarrolla rápidamente sobre la planta, dando
protección a la raíz, al fruto o al follaje, contra patógenos
como Pythium, Rhizoctonia, Fusarium, Verticillium y
Sclerotinia sclerotiorum y al follaje contra Botytis, Mildiús
vellosos y Colletotrichum de la mayoría de los cultivos.
Puede ser aplicado al suelo y al Follaje, TRICHO-PRO
se desarrolla rápidamente sobre la planta, dando
protección a la raíz, al fruto o al follaje, contra patógenos
como Pythium, Rhizoctonia, Fusarium, Verticillium y
Sclerotinia sclerotiorum y al follaje contra Botytis, Mildiús
vellosos y Colletotrichum de la mayoría de los cultivos.

TRICHO-PRO Su acción sobre los patógenos se genera mediante tres mecanismos: -como parasito directo sobre el patógeno. -producción de antibióticos naturales volátiles y no volátiles. (forma una coraza alrededor de la raíz de la planta) -competencia por espacio



BENEFICIOS:
Previene patógenos de la raíz (Pythium, Fusarium, Rhizoctonia, y Sclerotinia sclerotiorum) del follaje contra (Botytis, Mildiús vellosos y Colletotrichum) de los cultivos. No se ha registrado ningún efecto fitotóxico. Ideal para programas de producción orgánica, Está exento de tolerancia por la EPA y no tiene restricciones en tiempo para reentrar a la superficies tratadas. Disminuye o elimina la dependencia de fumigantes químicos. El ingrediente activo excreta enzimas y otros compuestos, que favorecen la solubilización de diferentes nutrientes, entre ellos el fosforo, que pasan a disposición de la planta. Promueve el crecimiento de pelos absorbentes y raíces alimenticias lo cual mejora la nutrición y la absorción de agua, generando cierta tolerancia al estrés hídrico y una mayor capacidad para absorber nutrientes, obteniendo un mayor crecimiento y desarrollo de las plantas.